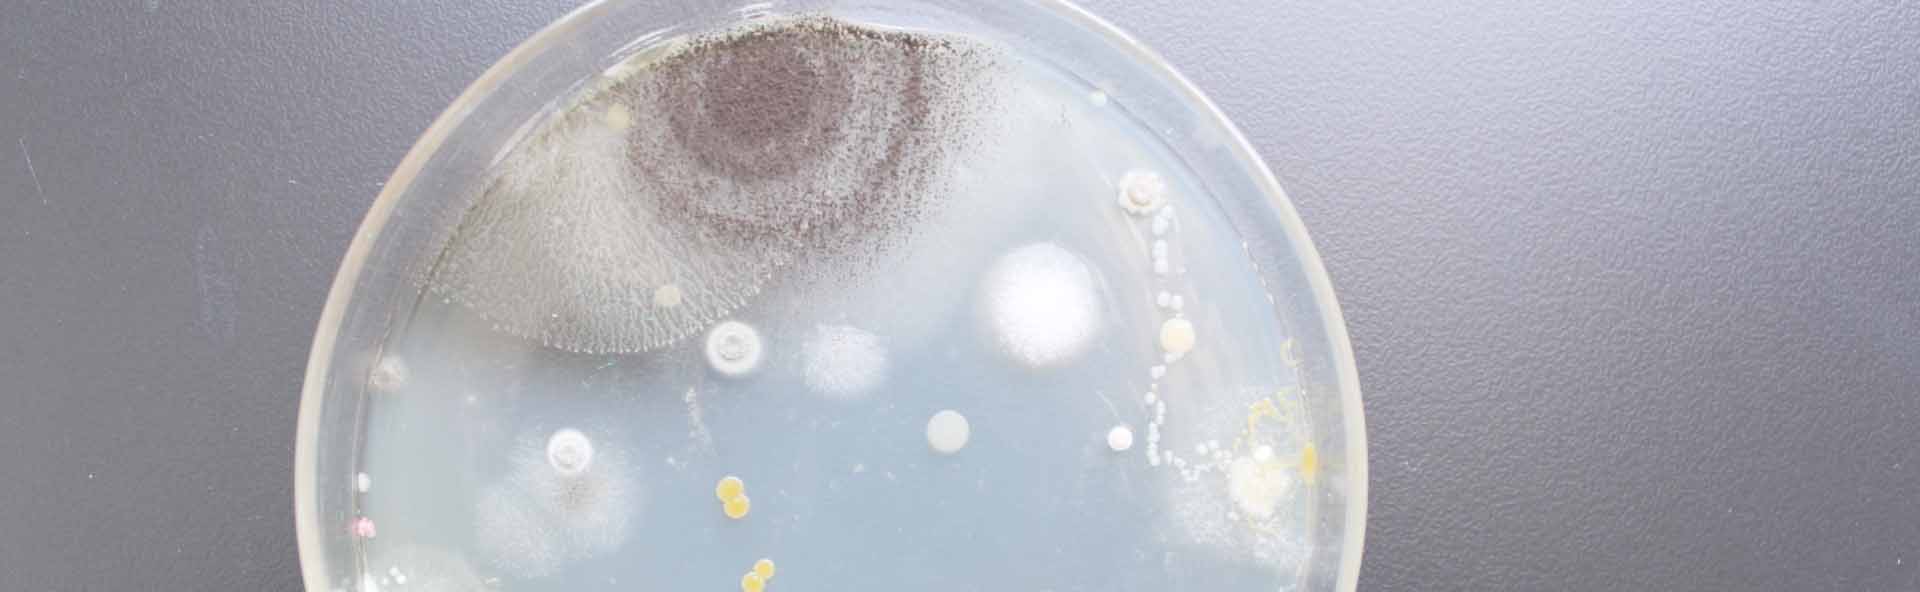

项目类型
-

抗菌技术在石料卫浴行业的应用
石料行业是建筑、装饰、园林等领域的重要供应商,石料产品广泛应用于室内外的墙面、地面、台面、家具等。然而,石料产品在使用过程中也会面临一些问题,如污染、变色、霉变等,这些问题不仅影响石料的美观和耐久性,还可能对人体健康造成危害。因此,石料行业需要采用有效的抗菌技术,以提高石料产品的品质和安全性。 -

抗菌技术在纺织行业的应用
抗菌纺织品是指经过特殊处理或添加抗菌剂,使其具有杀灭或抑制微生物生长的能力的纺织品。抗菌纺织品可以广泛应用于内衣、运动服、袜子、毛巾、鞋衬、医用纱布、手术服、床单、被套等领域,为人们提供清洁卫生、防臭防霉、防止交叉感染等多种效益。 -

抗菌技术在医疗行业的应用
抗菌技术是指利用各种物理、化学或生物方法,使材料或表面具有抑制或杀灭细菌、真菌、病毒等微生物的能力,从而提高卫生安全和防止感染的技术。抗菌技术在医疗行业的应用非常广泛,涉及到医疗器械、医用纺织品、医用涂层、医用包装等多个领域,为医疗保健和疾病防控提供了有效的解决方案。